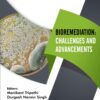
Bioremediation: Challenges and Advancements (EPUB)

By Raman Singh, Antresh Kumar, Kuldeep Singh 2-Deoxy-D-Glucose: Chemistry and Biology extensively examine 2-deoxy-D-glucose (2DG), a glucose analog with profound biomedical and therapeutic potential. This detailed resource covers 2DG’s chemical structure, methods of synthesis, and its pivotal roles in diagnostics and therapeutics. This book provides a comprehensive overview of the compound’s multifaceted uses, from antiviral applications to its emerging role in cancer treatment. Key Features:- Comprehensive coverage of 2DG synthesis, structure, and characterization.- Insights into 2DG’s diagnostic and therapeutic potential, including cancer and antiviral applications.- Exploration of its role in the Warburg effect and glycosylation inhibition.- Discussion on 2DG’s clinical applications, including COVID-19 treatments.
Product Details
Publisher : Bentham Science Publishers (November 15, 2024)
Language : English
Paperback : 267 pages
ISBN-10 : 9815305174
ISBN-13 : 978-9815305173

Reviews
There are no reviews yet.